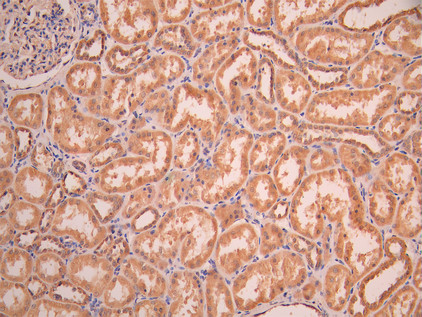

DLAT Recombinant Monoclonal Antibody
-
中文名稱:DLAT Recombinant Monoclonal Antibody
-
貨號:CSB-RA283972A0HU
-
規(guī)格:¥1320
-
圖片:
-
Western Blot
Positive WB detected in: HepG2 whole cell lysate(30μg), K562 whole cell lysate(30μg), COLO205 whole cell lysate(30μg), MCF7 whole cell lysate(30μg), Jurkat whole cell lysate(30μg), A549 whole cell lysate(30μg), PC-3 whole cell lysate(30μg), U251 whole cell lysate(30μg), Mouse brain tissue lysate(30μg)
All lanes:DLAT antibody at 1:1000
Secondary
Goat polyclonal to rabbit IgG at 1/40000 dilution
Predicted band size: 69 kDa
Observed band size: 69 kDa
Exposure time:2min -
IHC image of CSB-RA283972A0HU diluted at 1:100 and staining in paraffin-embedded human kidney tissue performed on a Leica BondTM system. After dewaxing and hydration, antigen retrieval was mediated by high pressure in a citrate buffer (pH 6.0). Section was blocked with 10% normal goat serum 30min at RT. Then primary antibody (1% BSA) was incubated at 4°C overnight. The primary is detected by a Goat anti-rabbit polymer IgG labeled by HRP and visualized using 0.05% DAB.
-
IHC image of CSB-RA283972A0HU diluted at 1:100 and staining in paraffin-embedded human liver cancer performed on a Leica BondTM system. After dewaxing and hydration, antigen retrieval was mediated by high pressure in a citrate buffer (pH 6.0). Section was blocked with 10% normal goat serum 30min at RT. Then primary antibody (1% BSA) was incubated at 4°C overnight. The primary is detected by a Goat anti-rabbit polymer IgG labeled by HRP and visualized using 0.05% DAB.
-
Overlay Peak curve showing MCF-7 cells stained with CSB-RA283972A0HU (red line) at 1:100. The cells were fixed in 4% formaldehyde and permeated by 0.2% TritonX-100 for 10min. Then 10% normal goat serum to block non-specific protein-protein interactions followed by the antibody (1ug/1*106cells) for 45min at 4℃. The secondary antibody used was FITC-conjugated goat anti-rabbit IgG (H+L) at 1/200 dilution for 35min at 4℃.Control antibody (green line) was Rabbit IgG (1ug/1*106cells) used under the same conditions. Acquisition of >10, 000 events was performed.
-
-
其他:
產(chǎn)品詳情
-
Uniprot No.:
-
基因名:DLAT
-
別名:70 kDa mitochondrial autoantigen of primary biliary cirrhosis antibody; Dihydrolipoamide acetyltransferase component of pyruvate dehydrogenase complex antibody; Dihydrolipoamide S Acetyltransferase antibody; Dihydrolipoyllysine-residue acetyltransferase component of pyruvate dehydrogenase complex antibody; dihydrolipoyllysine-residue acetyltransferase component of pyruvate dehydrogenase complex mitochondrial antibody; DLAT antibody; DLTA antibody; E2 antibody; E2 component of pyruvate dehydrogenase complex antibody; M2 antigen complex 70 kDa subunit antibody; mitochondrial antibody; ODP2_HUMAN antibody; PBC antibody; PDC E2 antibody; PDC-E2 antibody; PDCE2 antibody; Pyruvate dehydrogenase complex component E2 antibody; Pyruvate dehydrogenase complex E2 subunit antibody
-
反應(yīng)種屬:Human, Mouse
-
免疫原:A synthesized peptide from human DLAT protein
-
免疫原種屬:Homo sapiens (Human)
-
標(biāo)記方式:Non-conjugated
-
克隆類型:Monoclonal
-
抗體亞型:Rabbit IgG
-
純化方式:Affinity-chromatography
-
克隆號:5C6
-
濃度:It differs from different batches. Please contact us to confirm it.
-
保存緩沖液:Rabbit IgG in 10mM phosphate buffered saline , pH 7.4, 150mM sodium chloride, 0.05% BSA, 0.02% sodium azide and 50% glycerol.
-
產(chǎn)品提供形式:Liquid
-
應(yīng)用范圍:ELISA, WB, IHC, FC
-
推薦稀釋比:
Application Recommended Dilution WB 1:500-1:5000 IHC 1:50-1:200 FC 1:50-1:200 -
Protocols:
-
儲存條件:Upon receipt, store at -20°C or -80°C. Avoid repeated freeze.
-
貨期:Basically, we can dispatch the products out in 1-3 working days after receiving your orders. Delivery time maybe differs from different purchasing way or location, please kindly consult your local distributors for specific delivery time.
-
用途:For Research Use Only. Not for use in diagnostic or therapeutic procedures.
相關(guān)產(chǎn)品
靶點(diǎn)詳情
-
功能:The pyruvate dehydrogenase complex catalyzes the overall conversion of pyruvate to acetyl-CoA and CO(2), and thereby links the glycolytic pathway to the tricarboxylic cycle.
-
基因功能參考文獻(xiàn):
- DLAT interacts with C1QBP in mitochondria. PMID: 26753982
- ongoing activation of PDCE2-specific B-cells in primary biliary cirrhosis PMID: 25043065
- Results show that DLAT and ACAT2 as upstream acetyltransferases of K76 and K294 in 6PGD protein. PMID: 25042803
- These findings were used to identify potentially antigenic sequences within PDC-E2 (an important hepatic autoantigen) that contain a DR0801 motif. PMID: 23543758
- Solution structure and characterisation of the human pyruvate dehydrogenase complex core assembly PMID: 20361979
- Data suggest that the catalytic site of pyruvate dehydrogenase complex E2 rather than the previously reported lipoyl binding peptide may contain immunodominant epitopes recognized by antimitochondrial antibodies in primary biliary cirrhosis. PMID: 20180236
- a novel HLA-A*0201-restricted epitope PDC-E2 165 to 174 was defined in patients with primary biliary cirrhosis. PMID: 12395322
- study of facilitated interaction between the pyruvate dehydrogenase kinase isoform 2 and the dihydrolipoyl acetyltransferase PMID: 12816949
- model of the pyruvate dehydrogenase complex formed by E2 and E2 plus the E3-binding protein and binding of the E1 and E3 components PMID: 14638692
- Having found that there is an excellent and almost unique match between the PDC-E2 autoepitope and a sequence in mycobacterial hsp65s, we tested the corresponding peptides for cross-reactivity using sera from 90 Spanish and British PBC patients. PMID: 15120760
- This study report two unrelated patients with pyruvate dehydrogenase deficiency caused by defects in the E2 subunit. PMID: 16049940
- epitope specificity of these PDC-E2 autoantibodies was distinctive suggesting that the mechanisms leading to loss of tolerance in the transplantation patients are distinct from primary biliary cirrhosis PMID: 17068145
- Species specificity in the interaction between hE1beta and hE2 in pyruvate dehydrogenase complex. PMID: 18206651
- tissue specificity of the autoimmune injury in primary biliary cirrhosis is a consequence of the unique characteristics of HIBECs during apoptosis and can be explained by exposure to immune system of intact immunoreactive PDC-E2 within apoptotic blebs. PMID: 19185000
顯示更多
收起更多
-
相關(guān)疾病:Pyruvate dehydrogenase E2 deficiency (PDHE2 deficiency)
-
亞細(xì)胞定位:Mitochondrion matrix.
-
蛋白家族:2-oxoacid dehydrogenase family
-
數(shù)據(jù)庫鏈接:
Most popular with customers
-
YWHAB Recombinant Monoclonal Antibody
Applications: ELISA, WB, IHC, IF, FC
Species Reactivity: Human, Mouse, Rat
-
Phospho-YAP1 (S127) Recombinant Monoclonal Antibody
Applications: ELISA, WB, IHC
Species Reactivity: Human
-
-
-
-
-
-